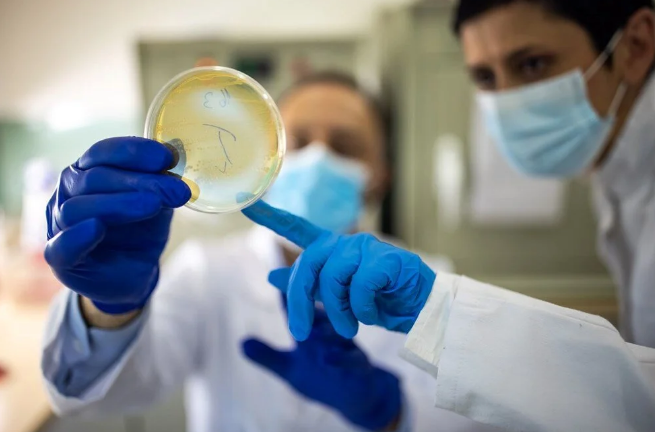
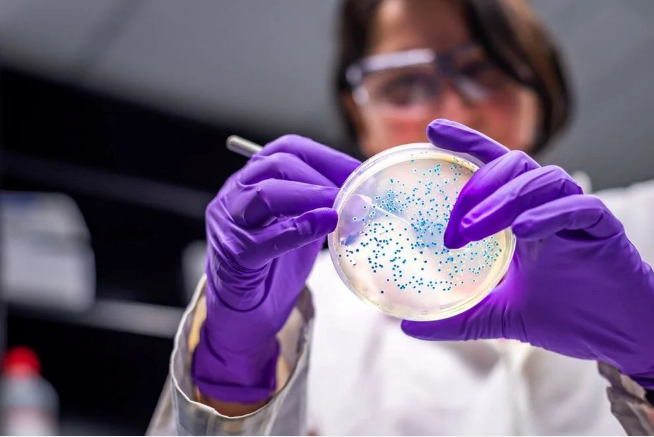
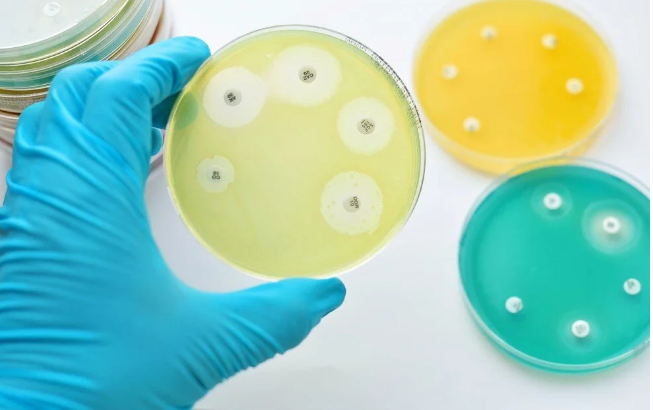
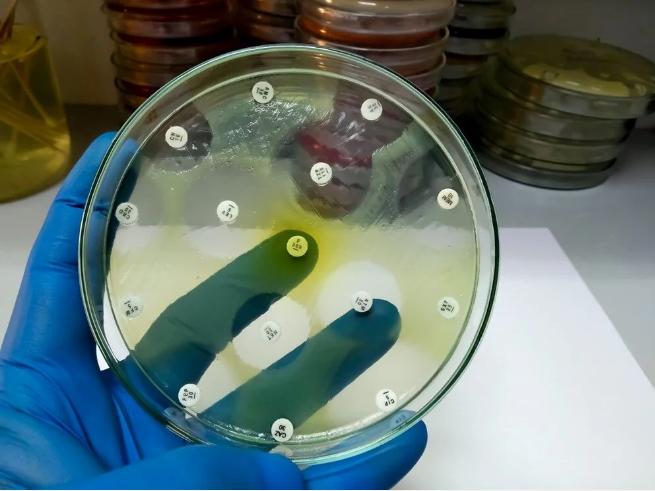

ŞİMDİYE KADAR YAPILAN EN GENİŞ KAPSAMLI ARAŞTIRMA
Antimikrobiyal direncin (AMR) küresel etkisine ilişkin şimdiye kadar yapılan en kapsamlı çalışmaya göre 2019'da 1,2 milyondan fazla insan antibiyotiğe dirençli bakteriyel enfeksiyonların doğrudan bir sonucu olarak öldü. 200'den fazla ülke ve bölgeyi kapsayan çalışma The Lancet'te yayımlandı.

AIDS'DEN DAHA FAZLA İNSANI ÖLDÜRDÜ
Bilim insanları, AMR nin HIV/AIDS veya sıtmadan daha fazla insanı öldürdüğünü vurgulayarak, önceden tedavi edilebilir enfeksiyonlar nedeniyle yüzbinlerce ölümün meydana geldiğini söyledi.
Araştımanın yazarlarından Prof. Dr. Chris Murray, “Bu yeni veriler dünya çapındaki antimikrobiyal direncin gerçek ölçeğini ortaya koyuyor. Bu tehditle mücadele etmek için şimdi harekete geçmemiz gerekiyor” dedi.
Bununla birlikte, Yeni Antimikrobiyal Direnç Araştırması ( Global Research on Antimicrobial Resistance) adlı araştırma, 2019 yılında 204 ülke ve bölgedeki 23 patojen ve 88 patojen-ilaç kombinasyonuna bağlı ölümleri tahmin etti.

470 MİLYONDAN FAZLA KİŞİNİN VERİLERİ İNCELENDİ
Çalışmada, sistematik literatür incelemelerinden, hastane sistemlerinden, gözetim sistemlerinden ve diğer veri kaynaklarından elde edilen 470 milyondan fazla bireysel kayıt incelendi.
Bulgular, AMR'nin dünya çapında tahmini 1,27 milyon ölümden doğrudan sorumlu olduğunu ve 2019'da tahmini 4,95 milyon ölümle ilişkili olduğunu gösterdi. 2019'da HIV/AIDS ve sıtmanın sırasıyla 860 bin ve 640 bin ölüme neden olduğu tahmin ediliyor.

HER BEŞ ÖLÜMDEN BİRİ ÇOCUK
Ayrıca, AMR her yaştan insan için bir tehdit oluştursa da küçük çocukların özellikle yüksek risk altında olduğu bulundu. AMR'ye atfedilebilecek her beş ölümden biri beş yaşın altındaki çocuklarda meydana geldi.

Diğer taraftan bilim insanları, AMR ile mücadele için acil önlem alınması gerektiğini vurguladı ve politika yapıcılar için hayat kurtarmaya ve sağlık sistemlerini korumaya yardımcı olacak acil eylemleri özetledi. Bunlar, mevcut antibiyotiklerin kullanımını optimize etmeyi, enfeksiyonları izlemek ve kontrol etmek için daha fazla önlem almayı, yeni antibiyotik ve tedaviler geliştirmek için daha fazla fon sağlamayı içeriyor.

İngiltere'nin antimikrobiyal direnç özel temsilcisi Dame Sally Davies, AMR'nin "insanlığın karşı karşıya olduğu en büyük zorluklardan biri" olduğunu belirterek. “Bu yeni sayıların arkasında, sessiz AMR salgınının yükünü trajik bir şekilde taşıyan aileler ve topluluklar var. Bu verileri her düzeyde harekete geçmek için bir uyarı sinyali olarak kullanmalıyız” dedi.
Öte yandan, bölgesel olarak, doğrudan AMR'nin neden olduğu ölümlerin, sırasıyla 100 bin kişi başına 24 ölüm ve 100 bin kişi başına 22 ölümle Sahra altı Afrika ve Güney Asya'da en yüksek olduğu tahmin edildi.

Yüksek gelirli ülkelerde, AMR doğrudan 100 bin kişide 13 ölüme yol açtı ve dolaylı olarak 100 bin kişide 56 ölümle ilişkilendirildi.














Yorum Yap